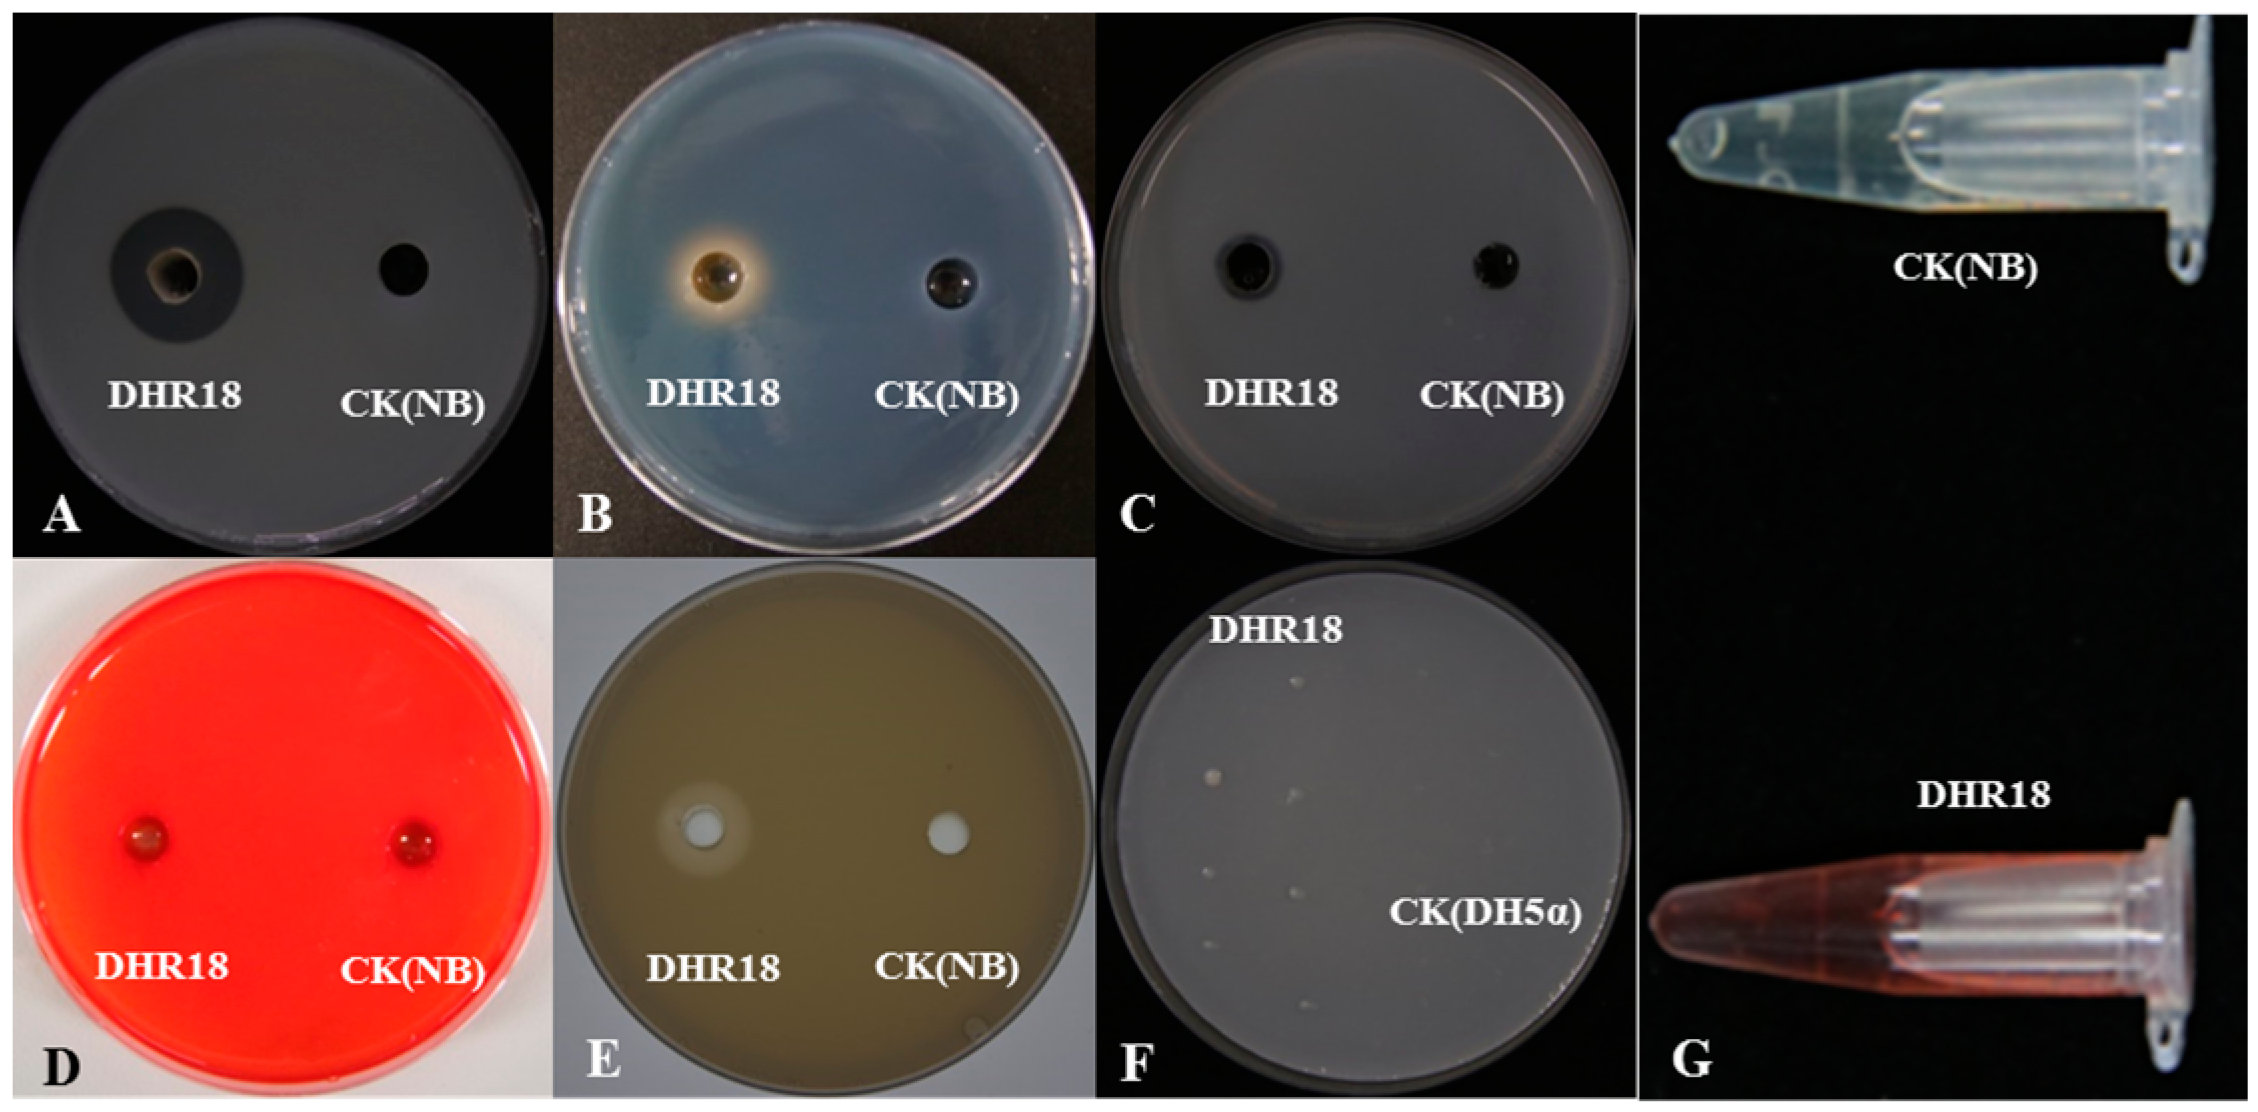
Microorganisms 12 01793 g005
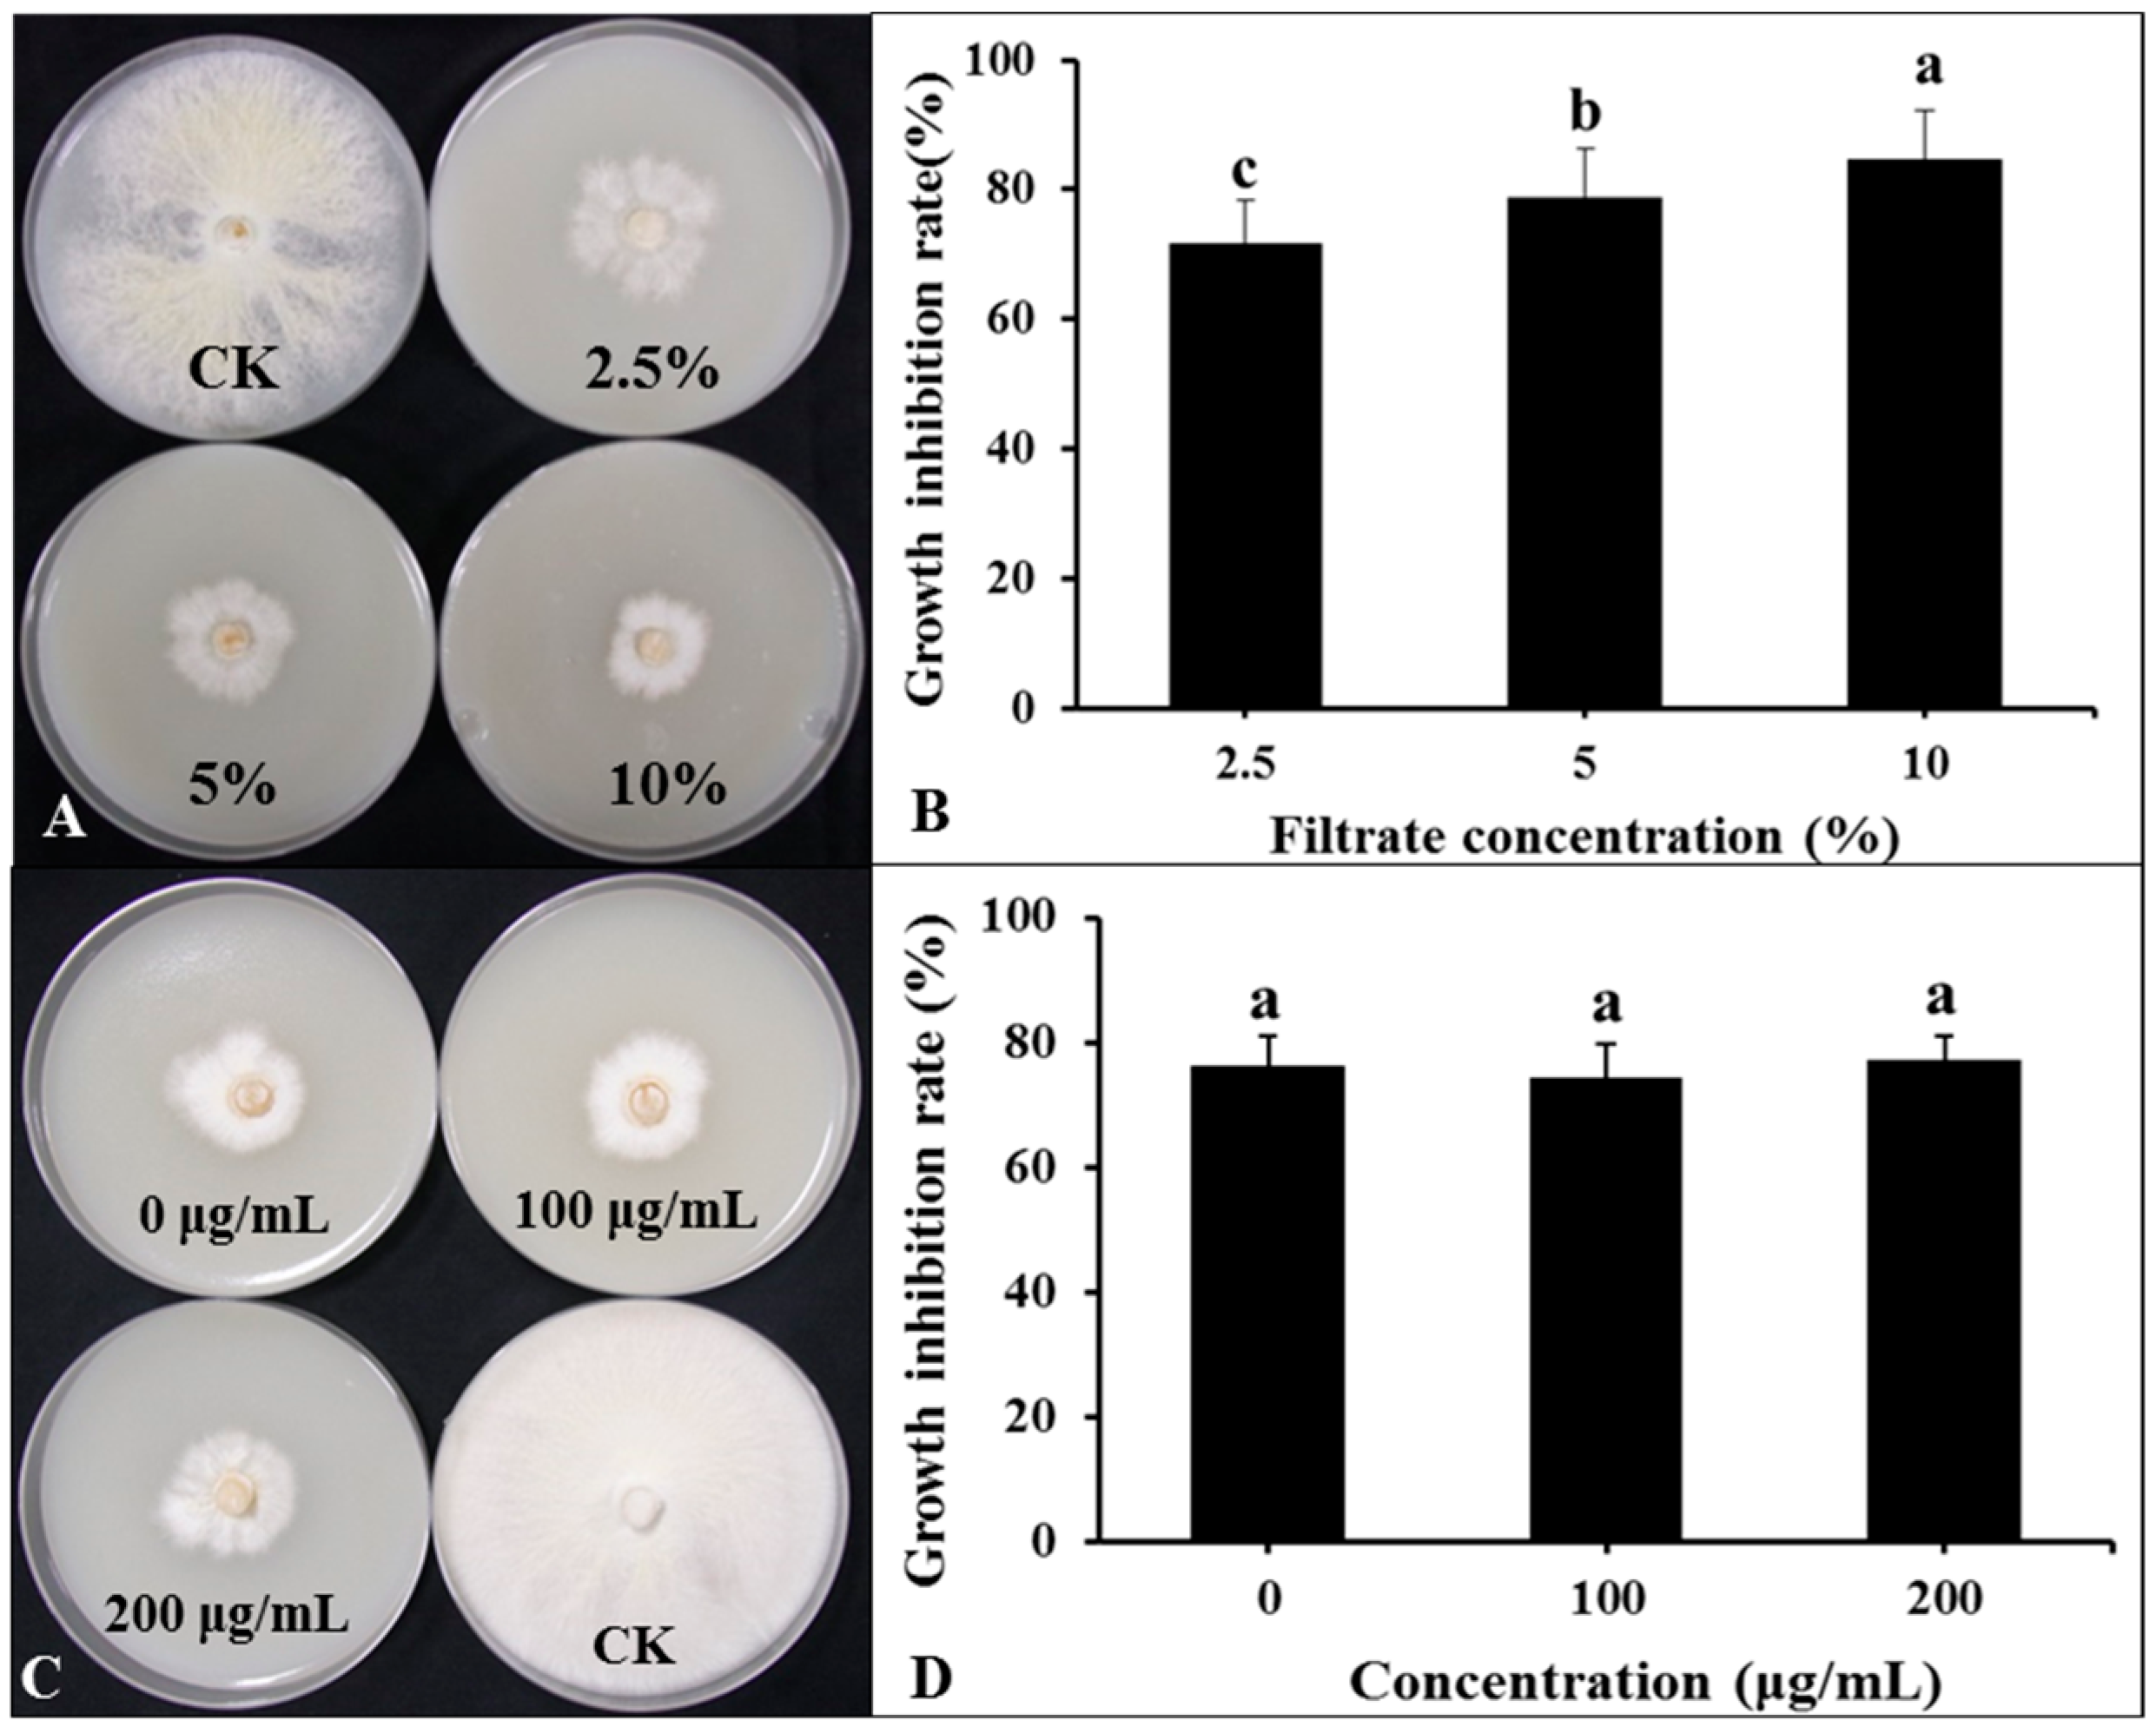
Microorganisms 12 01793 g007

Isolation, Identification, and Biocontrol Mechanisms of Endophytic Burkholderia arboris DHR18 from Rubber Tree against Red Root Rot Disease
Abstract
1. Introduction
2. Materials and Methods
2.1. Screening of Antagonistic Bacteria on Rubber Trees
2.2. Strain DHR18 Antifungal Spectrum
2.3. Effect of DHR18 on Rubber Red Root Diseases in the Greenhouse
2.4. Effect of DHR18 on Rubber Tree Seedling Growth in the Greenhouse
2.5. Analysis of the Characteristics of Endophytic Bacteria
2.5.1. Siderophore Production Determination
2.5.2. DHR18 Nitrogen Fixation Ability
2.5.3. DHR18 IAA Production
2.5.4. Detection of DHR18 Extracellular Enzymes
2.5.5. Determination of Phosphorus Dissolution Ability
2.5.6. Detection of DHR18 Biofilm Formation
2.6. DHR18 Genomic Sequencing and Annotation
2.7. Antibacterial Activity of DHR18 Secondary Metabolites
2.7.1. Antifungal Activity of Bacterial Culture Filtrate
2.7.2. Effect of Temperature on BCF Antagonistic Activity
2.7.3. Effect of Protease on the BCF Antagonistic Activity
2.7.4. Crude Extract Extraction and Detection of Antifungal Activity
2.8. Detection of the Defence-Related Enzyme Activities in Plants
2.9. Statistical Analysis
3. Results
3.1. Antagonistic Effect of DHR18 on G. pseudoferreum
3.2. Strain DHR18 Anti-Microbial Spectrum
3.3. Strain DHR18 Inhibitory Effect on Rubber Red Root Diseases in the Greenhouse
3.4. Effect of DHR18 Effect on Rubber Seedling Growth
3.5. Determination of Strain DHR18 Biological Characteristics
3.6. Strain DHR18 Genome Sequencing and Annotation
3.7. Effect of BCF on G. pseudoferreum Mycelial Growth
3.8. Detection of Antifungal Activity of Crude Extract
3.9. Effects of DHR18 on the Activity of Rubber Defence-Related Enzymes
4. Discussion
5. Conclusions
Supplementary Materials
Author Contributions
Funding
Data Availability Statement
Conflicts of Interest
References
- Puskas, J.E.; Cornish, K.; Kenzhe-Karim, B.; Mutalkhanov, M.; Kaszas, G.; Molnar, K. Natural rubber–Increasing diversity of an irreplaceable renewable resource. Heliyon 2024, 10, e25123. [Google Scholar] [CrossRef] [PubMed]
- Nandris, D.; Nicole, M.; Geiger, J. Root rot diseases. Plant Dis. 1987, 71, 298–306. [Google Scholar] [CrossRef]
- Mohammed, C.; Rimbawanto, A.; Page, D. Management of basidiomycete root—And stem—Rot diseases in oil palm, rubber and tropical hardwood plantation crops. For. Pathol. 2014, 44, 428–446. [Google Scholar] [CrossRef]
- Monkai, J.; Hyde, K.D.; Xu, J.; Mortimer, P.E. Diversity and ecology of soil fungal communities in rubber plantations. Fungal Biol. Rev. 2017, 31, 1–11. [Google Scholar] [CrossRef]
- Firmino, A.C.; Magalhães, I.P.; Gomes, M.E.; Fischer, I.H.; Junior, E.J.S.; Furtado, E.L. Monitoring Colletotrichum Colonization and Reproduction in Different Rubber Tree Clones. Plants 2022, 11, 905. [Google Scholar] [CrossRef] [PubMed]
- Komárek, M.; Čadková, E.; Chrastný, V.; Bordas, F.; Bollinger, J.-C. Contamination of vineyard soils with fungicides: A review of environmental and toxicological aspects. Environ. Int. 2010, 36, 138–151. [Google Scholar] [CrossRef]
- Piotrowska-Seget, Z.; Engel, R.; Nowak, E.; Kozdrój, J. Successive soil treatment with captan or oxytetracycline affects non-target microorganisms. World J. Microbiol. Biotechnol. 2008, 24, 2843–2848. [Google Scholar] [CrossRef]
- Shabbir, I.; Abd Samad, M.Y.; Othman, R.; Wong, M.-Y.; Sulaiman, Z.; Jaafar, N.M.; Bukhari, S.A.H. White root rot disease suppression in rubber plant with microbial co-inoculants and silicon addition. Rhizosphere 2020, 15, 100221. [Google Scholar] [CrossRef]
- Wang, M.; Zhang, Y.; Cai, H.; Zhao, X.; Zhu, Z.; Yan, Y.; Yin, K.; Cheng, G.; Li, Y.; Chen, G. A New Biocontrol Agent Bacillus velezensis SF334 against Rubber Tree Fungal Leaf Anthracnose and Its Genome Analysis of Versatile Plant Probiotic Traits. J. Fungi 2024, 10, 158. [Google Scholar] [CrossRef]
- Chu, L.; Lao, G.; Gao, X.; Liu, W.; Lu, Z.; Jin, P.; Miao, W. Bacillus velezensis HN-2 crude extract inhibits Erysiphe quercicola infection of rubber tree leaves. Physiol. Mol. Plant Pathol. 2022, 122, 101920. [Google Scholar] [CrossRef]
- Strobel, G.; Daisy, B.; Castillo, U.; Harper, J. Natural products from endophytic microorganisms. J. Nat. Prod. 2004, 67, 257–268. [Google Scholar] [CrossRef]
- Vílchez, J.I.; Lally, R.D.; Morcillo, R.J.L. Biosafety Evaluation: A Necessary Process Ensuring the Equitable Beneficial Effects of PGPR. In Advances in PGPR Research; CABI: Wallingford, UK, 2017; pp. 50–74. [Google Scholar]
- Kiros, T.; Ebu, S.M.; Melaku, Y.; Tesfa, T.; Dekebo, A. Isolation and identification of endophytic bacteria and associated compound from Gloriosa superba and their antibacterial activities. Heliyon 2023, 9, e22104. [Google Scholar] [CrossRef]
- de Carvalho, C.R.; Ferreira, M.C.; Amorim, S.S.; da Silva Florindo, R.H.; de Assis, J.C.S.; Zani, C.L.; Rosa, L.H. Bioactive Compounds of Endophytic Fungi Associated with Medicinal Plants. In Recent Advancement in White Biotechnology through Fungi: Perspective for Value-Added Products and Environments; Springer: Cham, Switzerland, 2019; Volume 2, pp. 303–361. [Google Scholar]
- Comby, M.; Gacoin, M.; Robineau, M.; Rabenoelina, F.; Ptas, S.; Dupont, J.; Profizi, C.; Baillieul, F. Screening of wheat endophytes as biological control agents against Fusarium head blight using two different in vitro tests. Microbiol. Res. 2017, 202, 11–20. [Google Scholar] [CrossRef]
- Martinez-Klimova, E.; Rodríguez-Peña, K.; Sánchez, S. Endophytes as sources of antibiotics. Biochem. Pharmacol. 2017, 134, 1–17. [Google Scholar] [CrossRef] [PubMed]
- Meng, X.-J.; Medison, R.G.; Cao, S.; Wang, L.-Q.; Cheng, S.; Tan, L.-T.; Sun, Z.-X.; Zhou, Y. Isolation, identification, and biocontrol mechanisms of endophytic Burkholderia vietnamiensis C12 from Ficus tikoua Bur against Rhizoctonia solani. Biol. Control 2023, 178, 105132. [Google Scholar] [CrossRef]
- Naik, S.; Shaanker, R.U.; Ravikanth, G.; Dayanandan, S. How and why do endophytes produce plant secondary metabolites? Symbiosis 2019, 78, 193–201. [Google Scholar] [CrossRef]
- Pal, G.; Saxena, S.; Kumar, K.; Verma, A.; Sahu, P.K.; Pandey, A.; White, J.F.; Verma, S.K. Endophytic Burkholderia: Multifunctional roles in plant growth promotion and stress tolerance. Microbiol. Res. 2022, 265, 127201. [Google Scholar] [CrossRef] [PubMed]
- Xu, Y.; Wang, L.; Liang, W.; Liu, M. Biocontrol potential of endophytic Bacillus velezensis strain QSE-21 against postharvest grey mould of fruit. Biol. Control 2021, 161, 104711. [Google Scholar] [CrossRef]
- Zhang, L.; Liu, Z.; Wang, Y.; Zhang, J.; Wan, S.; Huang, Y.; Yun, T.; Xie, J.; Wang, W. Biocontrol potential of endophytic Streptomyces malaysiensis 8ZJF-21 from medicinal plant against banana Fusarium wilt caused by Fusarium oxysporum f. sp. cubense tropical race 4. Front. Plant Sci. 2022, 13, 874819. [Google Scholar] [CrossRef] [PubMed]
- Zheng, T.-W.; Liu, L.; Nie, Q.-W.; Hsiang, T.; Sun, Z.-X.; Zhou, Y. Isolation, identification and biocontrol mechanisms of endophytic bacterium D61-A from Fraxinus hupehensis against Rhizoctonia solani. Biol. Control 2021, 158, 104621. [Google Scholar]
- Liu, L.; Medison, R.G.; Zheng, T.-W.; Meng, X.-J.; Sun, Z.-X.; Zhou, Y. Biocontrol potential of Bacillus amyloliquefaciens YZU-SG146 from Fraxinus hupehensis against Verticillium wilt of cotton. Biol. Control 2023, 183, 105246. [Google Scholar] [CrossRef]
- Wei, X.-H.; Nie, Q.-W.; Medison, R.G.; Zheng, T.-W.; Meng, X.-J.; Sun, Z.-X.; Zhou, Y. Evaluation of Pseudomonas koreensis B17-12 as a potential biological control agent against postharvest diseases of tomato. Physiol. Mol. Plant Pathol. 2024, 132, 102311. [Google Scholar] [CrossRef]
- Chen, L.; Shi, H.; Heng, J.; Wang, D.; Bian, K. Antimicrobial, plant growth-promoting and genomic properties of the peanut endophyte Bacillus velezensis LDO2. Microbiol. Res. 2019, 218, 41–48. [Google Scholar] [CrossRef]
- Livak, K.J.; Schmittgen, T.D. Analysis of relative gene expression data using real-time quantitative PCR and the 2−ΔΔCT method. Methods 2001, 25, 402–408. [Google Scholar] [CrossRef]
- Shin, S.H.; Lim, Y.; Lee, S.E.; Yang, N.W.; Rhee, J.H. CAS agar diffusion assay for the measurement of siderophores in biological fluids. J. Microbiol. Methods 2001, 44, 89–95. [Google Scholar] [CrossRef]
- Liaqat, F.; Eltem, R. Identification and characterization of endophytic bacteria isolated from in vitro cultures of peach and pear rootstocks. 3 Biotech 2016, 6, 120. [Google Scholar] [CrossRef]
- Kong, P.; Hong, C. Endophytic Burkholderia sp. SSG as a potential biofertilizer promoting boxwood growth. PeerJ 2020, 8, e9547. [Google Scholar] [CrossRef]
- Jangir, M.; Pathak, R.; Sharma, S.; Sharma, S. Biocontrol mechanisms of Bacillus sp., isolated from tomato rhizosphere, against Fusarium oxysporum f. sp. lycopersici. Biol. Control 2018, 123, 60–70. [Google Scholar] [CrossRef]
- Zheng, Y.; Xue, Q.-Y.; Xu, L.-L.; Xu, Q.; Lu, S.; Gu, C.; Guo, J.-H. A screening strategy of fungal biocontrol agents towards Verticillium wilt of cotton. Biol. Control 2011, 56, 209–216. [Google Scholar] [CrossRef]
- Guo, X.; Chen, D.-D.; Peng, K.-S.; Cui, Z.-W.; Zhang, X.-J.; Li, S.; Zhang, Y.-A. Identification and characterization of Bacillus subtilis from grass carp (Ctenopharynodon idellus) for use as probiotic additives in aquatic feed. Fish Shellfish Immunol. 2016, 52, 74–84. [Google Scholar] [CrossRef]
- Nautiyal, C.S. An efficient microbiological growth medium for screening phosphate solubilizing microorganisms. FEMS Microbiol. Lett. 1999, 170, 265–270. [Google Scholar] [CrossRef]
- Wang, L.; Li, X.; Medison, R.G.; Zheng, T.; Meng, X.; Sun, Z.; Zhou, Y. Biocontrol efficacy of Burkholderia pyrrocinia S17-377 in controlling rice sheath blight. Biol. Control 2023, 187, 105368. [Google Scholar] [CrossRef]
- Seemann, T. Prokka: Rapid prokaryotic genome annotation. Bioinformatics 2014, 30, 2068–2069. [Google Scholar] [CrossRef]
- Meng, X.-j.; Wang, L.-q.; Ma, B.-g.; Wei, X.-h.; Zhou, Y.; Sun, Z.-x.; Li, Y.-y. Screening, identification and evaluation of an acidophilic strain of Bacillus velezensis B4-7 for the biocontrol of tobacco bacterial wilt. Front. Plant Sci. 2024, 15, 1360173. [Google Scholar] [CrossRef]
- Alam, K.; Islam, M.M.; Gong, K.; Abbasi, M.N.; Li, R.; Zhang, Y.; Li, A. In silico genome mining of potential novel biosynthetic gene clusters for drug discovery from Burkholderia bacteria. Comput. Biol. Med. 2022, 140, 105046. [Google Scholar] [CrossRef]
- Kandel, S.L.; Firrincieli, A.; Joubert, P.M.; Okubara, P.A.; Leston, N.D.; McGeorge, K.M.; Mugnozza, G.S.; Harfouche, A.; Kim, S.-H.; Doty, S.L. An in vitro study of bio-control and plant growth promotion potential of Salicaceae endophytes. Front. Microbiol. 2017, 8, 386. [Google Scholar] [CrossRef]
- Kim, H.; Mohanta, T.K.; Park, Y.-H.; Park, S.-C.; Shanmugam, G.; Park, J.-S.; Jeon, J.; Bae, H. Complete genome sequence of the mountain-cultivated ginseng endophyte Burkholderia stabilis and its antimicrobial compounds against ginseng root rot disease. Biol. Control 2020, 140, 104126. [Google Scholar] [CrossRef]
- Kong, P.; Hong, C. A potent Burkholderia endophyte against boxwood blight caused by Calonectria pseudonaviculata. Microorganisms 2020, 8, 310. [Google Scholar] [CrossRef]
- Yu, X.; Ai, C.; Xin, L.; Zhou, G. The siderophore-producing bacterium, Bacillus subtilis CAS15, has a biocontrol effect on Fusarium wilt and promotes the growth of pepper. Eur. J. Soil Biol. 2011, 47, 138–145. [Google Scholar] [CrossRef]
- Zhang, C.; Lin, Y.; Tian, X.; Xu, Q.; Chen, Z.; Lin, W. Tobacco bacterial wilt suppression with biochar soil addition associates to improved soil physiochemical properties and increased rhizosphere bacteria abundance. Appl. Soil Ecol. 2017, 112, 90–96. [Google Scholar] [CrossRef]
- Ziane, S.O.; Imehli, Z.; Talibi, Z.E.A.; Koraichi, S.I.; Meddich, A.; El Modafar, C. Biocontrol of tomato Verticillium wilt disease by plant growth-promoting bacteria encapsulated in alginate extracted from brown seaweed. Int. J. Biol. Macromol. 2024, 276, 133800. [Google Scholar]
- Ruiz-Herrera, J.; Victoria Elorza, M.; Valentín, E.; Sentandreu, R. Molecular organization of the cell wall of Candida albicans and its relation to pathogenicity. FEMS Yeast Res. 2006, 6, 14–29. [Google Scholar] [CrossRef]
- Sahu, P.K.; Singh, S.; Gupta, A.R.; Gupta, A.; Singh, U.B.; Manzar, N.; Bhowmik, A.; Singh, H.V.; Saxena, A.K. Endophytic bacilli from medicinal-aromatic perennial Holy basil (Ocimum tenuiflorum L.) modulate plant growth promotion and induced systemic resistance against Rhizoctonia solani in rice (Oryza sativa L.). Biol. Control 2020, 150, 104353. [Google Scholar] [CrossRef]
- Beneduzi, A.; Ambrosini, A.; Passaglia, L.M. Plant growth-promoting rhizobacteria (PGPR): Their potential as antagonists and biocontrol agents. Genet. Mol. Biol. 2012, 35, 1044–1051. [Google Scholar] [CrossRef]
- Radzki, W.; Gutierrez Mañero, F.; Algar, E.; Lucas García, J.; García-Villaraco, A.; Ramos Solano, B. Bacterial siderophores efficiently provide iron to iron-starved tomato plants in hydroponics culture. Antonie Leeuwenhoek 2013, 104, 321–330. [Google Scholar] [CrossRef]
- Skariyachan, S.; Sridhar, V.S.; Packirisamy, S.; Kumargowda, S.T.; Challapilli, S.B. Recent perspectives on the molecular basis of biofilm formation by Pseudomonas aeruginosa and approaches for treatment and biofilm dispersal. Folia Microbiol. 2018, 63, 413–432. [Google Scholar] [CrossRef]
- Sun, D.; Zhuo, T.; Hu, X.; Fan, X.; Zou, H. Identification of a Pseudomonas putida as biocontrol agent for tomato bacterial wilt disease. Biol. Control 2017, 114, 45–50. [Google Scholar] [CrossRef]
- Simonetti, E.; Alvarez, F.; Feldman, N.; Vinacour, M.; Roberts, I.N.; Ruiz, J.A. Genomic insights into the potent antifungal activity of B. ambifaria T16. Biol. Control 2021, 155, 104530. [Google Scholar] [CrossRef]
- Jia, J.; Ford, E.; Hobbs, S.M.; Baird, S.M.; Lu, S.-E. Occidiofungin is the key metabolite for antifungal activity of the endophytic bacterium Burkholderia sp. MS455 against Aspergillus flavus. Phytopathology 2022, 112, 481–491. [Google Scholar] [CrossRef]
- Vaillancourt, M.; Limsuwannarot, S.; Jorth, P. 101 Pyochelin-overexpressing Pseudomonas aeruginosa mutants evade immune clearance by inducing macrophage ferroptosis. J. Cyst. Fibros. 2023, 22, S53. [Google Scholar] [CrossRef]
- Wang, J.; Wang, Y.; Lou, H.; Wang, W. AlgU controls environmental stress adaptation, biofilm formation, motility, pyochelin synthesis and antagonism potential in Pseudomonas protegens SN15-2. Microbiol. Res. 2023, 272, 127396. [Google Scholar] [CrossRef]
- Wang, X.; Zhang, M.; Loh, B.; Leptihn, S.; Ahmed, T.; Li, B. A novel NRPS cluster, acquired by horizontal gene transfer from algae, regulates siderophore iron metabolism in Burkholderia seminalis R456. Int. J. Biol. Macromol. 2021, 182, 838–848. [Google Scholar] [CrossRef]
- Wang, X.; Zhou, H.; Ren, X.; Chen, H.; Zhong, L.; Bai, X.; Bian, X. Recombineering enables genome mining of novel siderophores in a non-model Burkholderiales strain. Eng. Microbiol. 2023, 3, 100106. [Google Scholar] [CrossRef]
- Arima, K.; Imanaka, H.; Kousaka, M.; Fukuta, A.; Tamura, G. Pyrrolnitrin, a new antibiotic substance, produced by Pseudomonas. Agric. Biol. Chem. 1964, 28, 575–576. [Google Scholar] [CrossRef]
- Mousa, W.K.; Raizada, M.N. Biodiversity of genes encoding anti-microbial traits within plant associated microbes. Front. Plant Sci. 2015, 6, 135014. [Google Scholar] [CrossRef]
- Richter, H.; Lieberei, R.; Strnad, M.; Novák, O.; Gruz, J.; Rensing, S.A.; von Schwartzenberg, K. Polyphenol oxidases in Physcomitrella: Functional PPO1 knockout modulates cytokinin-dependent developmentin the moss Physcomitrella patens. J. Exp. Bot. 2012, 63, 5121–5135. [Google Scholar] [CrossRef]
- Shine, M.; Yang, J.W.; El-Habbak, M.; Nagyabhyru, P.; Fu, D.Q.; Navarre, D.; Ghabrial, S.; Kachroo, P.; Kachroo, A. Cooperative functioning between phenylalanine ammonia lyase and isochorismate synthase activities contributes to salicylic acid biosynthesis in soybean. New Phytol. 2016, 212, 627–636. [Google Scholar] [CrossRef]
- Singh, R.; Sunder, S.; Kumar, P. Sheath blight of rice: Current status and perspectives. Indian Phytopathol 2016, 69, 340–351. [Google Scholar]
- Xu, S.; Kim, B.-S. Evaluation of Paenibacillus polymyxa strain SC09-21 for biocontrol of Phytophthora blight and growth stimulation in pepper plants. Trop. Plant Pathol. 2016, 41, 162–168. [Google Scholar] [CrossRef]
- Zhang, J.; Chen, L.; Fu, C.; Wang, L.; Liu, H.; Cheng, Y.; Li, S.; Deng, Q.; Wang, S.; Zhu, J. Comparative transcriptome analyses of gene expression changes triggered by Rhizoctonia solani AG1 IA infection in resistant and susceptible rice varieties. Front. Plant Sci. 2017, 8, 1422. [Google Scholar] [CrossRef]

| Pathogenic Fungi | Antibacterial Bandwidth (mm) | Inhibition Rate (%) |
|---|---|---|
| Botrytis cinerea | 14.12 ± 1.15 | 82.22 ± 2.78 a |
| Magnaporthe oryzae | 12.74 ± 0.80 | 78.89 ± 1.93 b |
| Colletotrichum siamense | 9.70 ± 1.37 | 71.56 ± 3.31 d |
| Colletotrichum phomoides | 12.10 ± 1.54 | 77.33 ± 3.71 b |
| Colletotrichum australisinense | 11.45 ± 1.08 | 75.78 ± 2.61 bc |
| Fusarium graminearum | 10.62 ± 1.86 | 73.78 ± 4.48 cd |
| Treatment | Relative Lesion Area (%) | Control Efficacy (%) | Relative Expression | Control Efficacy (%) |
|---|---|---|---|---|
| Tridemorph | 32.47 ± 3.72 | 65.26 a | 10.26 ± 1.23 | 70.99 a |
| DHR18 (Q3) | 35.42 ± 6.21 | 62.11 a | 12.41 ± 1.78 | 64.90 a |
| DHR18 (Q2) | 71.35 ± 7.31 | 23.13 b | 21.78 ± 2.74 | 38.40 b |
| DHR18 (Q1) | 80.33 ± 8.24 | 14.07 c | 27.86 ± 2.55 | 21.21 c |
| CK | 93.48 ± 12.41 | - | 35.36 ± 3.21 |
| Growth Parameter | T3 | T2 | T1 | CK |
|---|---|---|---|---|
| Plant height (mm) | 34.27 ± 2.31 a | 33.45 ± 1.98 ab | 32.78 ± 1.06 ab | 30.69 ± 1.36 b |
| Root length (mm) | 13.45 ± 1.25 a | 11.78 ± 1.13 b | 11.36 ± 0.87 b | 11.23 ± 0.69 b |
| Fresh weight (g) | 5.78 ± 0.45 a | 5.41 ± 0.32 a | 5.34 ± 0.64 ab | 5.08 ± 0.47 b |
| Dry weight (g) | 2.47 ± 0.14 a | 2.21 ± 0.11 ab | 2.12 ± 0.14 ab | 2.07 ± 0.21 b |
| Number of root system | 22.3 ± 3.4 a | 17.6 ± 2.1 b | 11.8 ± 1.7 c | 9.2 ± 1.6 d |
| Type | Start | End | Similar Cluster | Similarity |
|---|---|---|---|---|
| NRP-metallophore, NRPS | 1,737,336 | 1,802,333 | Ornibactin C8/C6/C4 | 100% |
| NRP-metallophore, NRPS | 106,666 | 160,518 | Pyochelin | 100% |
| Other | 1,084,700 | 1,125,785 | Pyrrolnitrin | 100% |
| NRPS, T1PKS, betalactone | 539,589 | 675,375 | Occidiofungin A | 88% |
| NRPS, transAT-PKS | 1,243,460 | 1,264,524 | N-acyloxyacyl Glutamine | 50% |
| Terpene | 761,188 | 808,822 | Capsular polysaccharide | 16% |
| phosphonate | 1,413,306 | 1,446,017 | Dehydrofosmidomycin | 15% |
| Arylpolyene | 3,128,937 | 3,170,148 | APE Vf | 10% |
| acyl_amino_acids | 3,144,169 | 3,205,188 | Pf-5 pyoverdine | 1% |
| NRPS-like, NRPS, T1PKS | 1,849,817 | 1,902,941 | - | - |
| Terpene | 2,002,539 | 2,023,564 | - | - |
| Hserlactone | 523,186 | 543,794 | - | - |
| NRPS-like, hydrogen-cyanide | 2,038,092 | 2,091,743 | - | - |
Disclaimer/Publisher’s Note: The statements, opinions and data contained in all publications are solely those of the individual author(s) and contributor(s) and not of MDPI and/or the editor(s). MDPI and/or the editor(s) disclaim responsibility for any injury to people or property resulting from any ideas, methods, instructions or products referred to in the content. |
© 2024 by the authors. Licensee MDPI, Basel, Switzerland. This article is an open access article distributed under the terms and conditions of the Creative Commons Attribution (CC BY) license (https://creativecommons.org/licenses/by/4.0/).
Share and Cite
Meng, X.; Luo, Y.; Zhao, X.; Fu, Y.; Zou, L.; Cai, H.; Zhou, Y.; Tu, M. Isolation, Identification, and Biocontrol Mechanisms of Endophytic Burkholderia arboris DHR18 from Rubber Tree against Red Root Rot Disease. Microorganisms 2024, 12, 1793. https://doi.org/10.3390/microorganisms12091793
Meng X, Luo Y, Zhao X, Fu Y, Zou L, Cai H, Zhou Y, Tu M. Isolation, Identification, and Biocontrol Mechanisms of Endophytic Burkholderia arboris DHR18 from Rubber Tree against Red Root Rot Disease. Microorganisms. 2024; 12(9):1793. https://doi.org/10.3390/microorganisms12091793
Chicago/Turabian StyleMeng, Xiangjia, Youhong Luo, Xinyang Zhao, Yongwei Fu, Lifang Zou, Haibin Cai, Yi Zhou, and Min Tu. 2024. "Isolation, Identification, and Biocontrol Mechanisms of Endophytic Burkholderia arboris DHR18 from Rubber Tree against Red Root Rot Disease" Microorganisms 12, no. 9: 1793. https://doi.org/10.3390/microorganisms12091793
APA StyleMeng, X., Luo, Y., Zhao, X., Fu, Y., Zou, L., Cai, H., Zhou, Y., & Tu, M. (2024). Isolation, Identification, and Biocontrol Mechanisms of Endophytic Burkholderia arboris DHR18 from Rubber Tree against Red Root Rot Disease. Microorganisms, 12(9), 1793. https://doi.org/10.3390/microorganisms12091793

